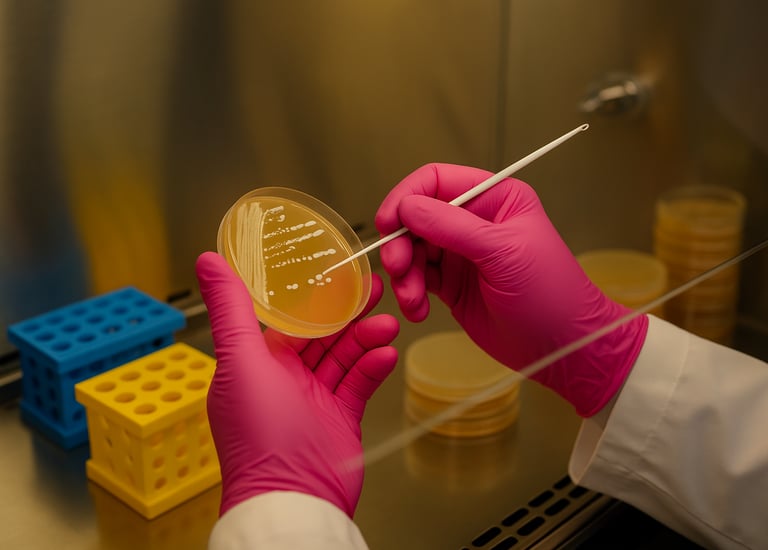
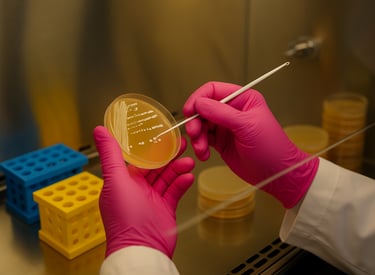

Projetos Inovadores
Oferecemos soluções em identificação microbiana, análises genéticas ambientais e engenharia de microrganismos com edição genômica para aplicações específicas.
Identificação Rápida
Resultados rápidos e precisos utilizando a plataforma Oxford Nanopore

Desenvolvimento Especializado
Microrganismos geneticamente modificados para eficiência industrial e aplicações na agricultura, utilizando técnicas de edição de genoma.




Setores Agroindustriais
Soluções para unidades de fermentação e identificação de espécies e contaminações.
Sustentabilidade Ambiental
Identificação de animais e vegetais em nível de espécies utlizando estratégias com barcodes e amostras difíceis (vestígios).
→
→
→
→
Serviços
Identificação rápida e precisa de microrganismos.
Análises de DNA ambiental
Contrução de linhagens de microorganismos personalizadas com edição de genoma
Inovação
Qualidade
contato@ampliomics.com.br
+55 19 99907 0104
© 2025. All rights reserved.
AMPLIOMICS PESQUISA E DESENVOLVIMENTO LTDA
CNPJ 60.345.440/0001-02 / Inscrição Municipal 17759374
Endereço Comercial: AV PAULISTA, 1636, CONJ 4, PAVMTO 15, SALA 1504, COND. PAULISTA CORPORATE
Bela Vista, São Paulo - SP
CEP 01.310-200
